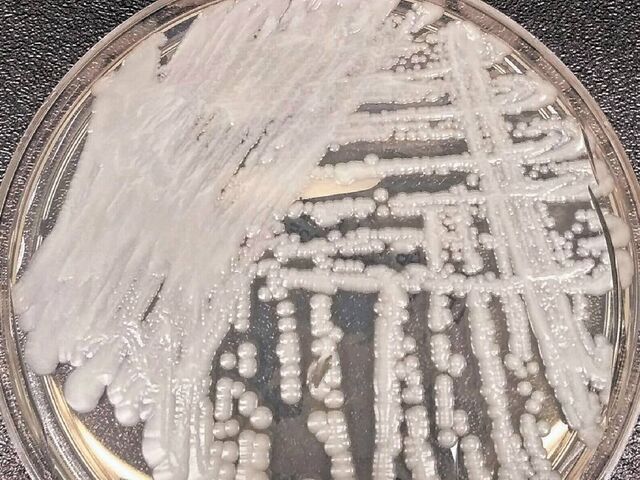

Record Number of Candida Auris Cases Reported in Southern Nevada in January 2023
ICARO Media Group
January 2023 marked a significant increase in the number of Candida auris cases reported by hospitals and nursing homes in Southern Nevada, according to data from the Nevada Division of Public and Behavioral Health. A record high of 69 invasive infections and 133 colonization cases of the potentially fatal fungus were reported last month. This surge in cases may be attributed to reporting lags and the implementation of a new state regulation mandating the reporting of cases.
First reported in August 2021, the number of clinical cases of C. auris had been steadily rising in 2021 and 2022 before reaching a peak of 63 in October 2022, followed by a slight decline. Health officials also noted a rise in colonization cases, detected through screening individuals without symptoms.
Sunrise Hospital and Medical Center, the largest acute-care facility in Nevada, reported the highest number of cases in the state and has been actively screening at-risk patients for the fungus. Dr. Steven Merta, the hospital's chief medical officer, stated that they began weekly testing of burn patients in January 2023, surpassing CDC recommendations.
The Centers for Disease Control and Prevention (CDC) flagged the spread of the drug-resistant fungus as alarming, with a tripling in the number of cases resistant to recommended antifungal treatments. Mark Pandori, director of the Nevada State Public Health Laboratory, highlighted the continuous mutation of the fungus, making existing drugs less effective and allowing it to spread and evolve.
Data shows that there have been 1,085 clinical cases and 1,785 colonizations of C. auris reported in Nevada since 2021, with the majority of cases concentrated in Southern Nevada. Although more than one in three people with an invasive infection die, it is challenging to determine the cause of death in C. auris cases, and the state is no longer disclosing the number of deaths associated with the fungus.
Despite proactive efforts to detect and control the spread of Candida auris, the state has faced challenges in managing the outbreaks. For more information on the Candida auris outbreaks in Southern Nevada, visit lvrj.com/superbug.


